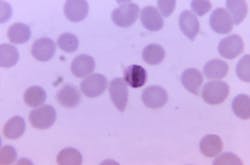
Courtesy of the CDC Courtesy of the CDC

One injection with an investigational monoclonal antibody (mAb) may be safe and effective at preventing infection in adults exposed to malaria, according to findings from a phase 1 clinical trial published recently in the New England Journal of Medicine. Investigators from NIH’s Vaccine Research Center developed the antibody, known as L9LS, and led the trial.
L9LS is a laboratory-made version of a naturally occurring antibody called L9, derived from the blood of a volunteer who had received an investigational malaria vaccine. L9LS prevents malaria by neutralizing the parasites in the skin and blood before they can infect liver cells.
In this trial, 17 adult volunteers received an intravenous or subcutaneous dose of either 1 mg, 5 mg, or 20 mg per kilogram of body weight of L9LS. Within 2 to 6 weeks of mAb administration, the participants treated with L9LS and six control participants underwent controlled human malaria infection in which they were exposed to mosquitoes carrying the Plasmodium falciparum parasite.
Of the 17 participants, 15 (88%) were protected after controlled human malaria infection after 21 days. Parasitemia did not develop in any of the participants who received 5 or 20 mg per kilogram of intravenous L9LS. However, one participant who received 1 mg per kilogram intravenously, one participant who received 5 mg per kilogram subcutaneously, and all six control participants developed parasitemia. All were treated without incident.
According to NIH, L9LS is similar to another VRC-developed anti-malarial antibody, CIS43LS, that is highly protective against malaria when administered intravenously. However, L9LS is two to three times more potent than CIS43LS. The increased potency allows for subcutaneous injection, which may be a more cost-effective and feasible route of administration.